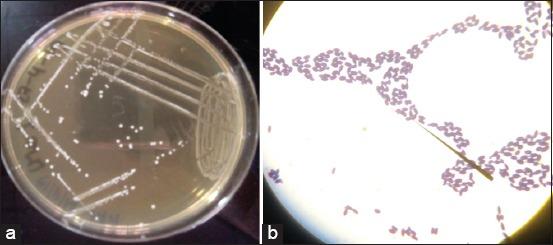

assessment of antibacterial activity from spp. against virulent species isolated from slaughter animals in Benin.
作者信息
Agbankpe Alidehou Jerrold, Dougnon Tamegnon Victorien, Balarabe Roubaya, Deguenon Esther, Baba-Moussa Lamine
机构信息
Research Unit in Applied Microbiology and Pharmacology of Natural Substances, Research Laboratory in Applied Biology, Polytechnic School of Abomey-Calavi, University of Abomey-Calavi, Cotonou, Benin.
Laboratory of Biology and Molecular Typing in Microbiology, Faculty of Science and Technology, University of Abomey-Calavi, Cotonou, Benin.
出版信息
Vet World. 2019 Dec;12(12):1951-1958. doi: 10.14202/vetworld.2019.1951-1958. Epub 2019 Dec 13.
BACKGROUND AND AIM
spp. are among the world's leading foodborne pathogens, found naturally in the intestines of many animals. Lactic acid bacteria, mainly , are a promising alternative to antibiotics for animal and human health. This study aimed to assess the antibacterial activity of spp. strains against virulent spp. isolated from slaughter animals in Benin.
MATERIALS AND METHODS
Eleven samples of raw cow's milk, five samples of breast milk, and six infant stool samples were taken. From these samples, strains of were isolated and identified. The probiotic potential of each of the identified strains was characterized, and finally antibacterial activity of these strains was evaluated against three virulent strains of spp. and a reference strain of Typhimurium ATCC 14028.
RESULTS
Out of the 22 samples collected, 20 strains of spp. were isolated and identified. These strains included (30%), (25%), (25%), (15%), and (05%). Characterization of the probiotic potential of these strains showed that only 16 strains were resistant to pH=1.5. Fourteen of them were able to withstand the simulated gastric juice (pH 1.5+pepsin). The 14 probiotic strains showed very good antibacterial activity against virulent strains of spp. with inhibition zone diameters ranging from 12.36±0.03 mm to 35.33±0.05 mm (R values>6 mm).
CONCLUSION
From this study, strains isolated from raw cow milk, breast milk, and infantile stool might be used as some valid candidates for probiotics. It also represents good alternatives for antibiotics in the fight against animal and human salmonellosis.